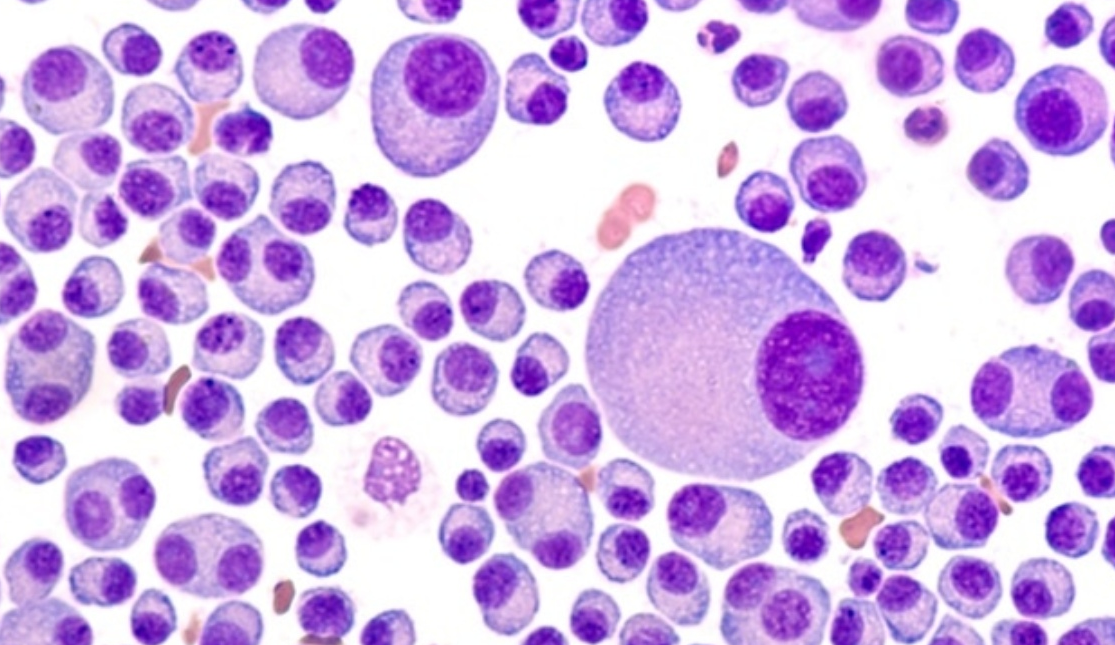
Πολλαπλό μυέλωμα

Με πολλαπλό μυέλωμα διαγνώστηκε η Ντόρα Μπακογιάννη, κάτι που γνωστοποίησε η ίδια με ανάρτησή της στα social media.
Το πολλαπλό μυέλωμα αποτελεί μία κακοήθεια των πλασματοκυττάρων. Τα πλασματοκύτταρα, είναι κύτταρα που υπό φυσιολογικές συνθήκες παράγουν τα αντισώματα, πρωτεΐνες δηλαδή που είναι ειδικευμένες για να «προσκολλώνται» σε διαφορετικό για κάθε μια αντιγόνο (ξένη πρωτεΐνη), όπως σε αντιγόνα μικροβιών, ιών, κτλ, με αποτέλεσμα να απενεργοποιούν αυτά τα αντιγόνα ή να στρέφουν άλλα κύτταρα του ανοσοποιητικού έναντι αυτών των «εχθρικών» αντιγόνων που βρίσκονται π.χ. στην επιφάνεια των ιών ή των μικροβίων.
Στην περίπτωση όμως του πολλαπλού μυελώματος, τα πλασματοκύτταρα υφίσταται κακοήθη εξαλλαγή.
Τα κακοήθη πλασματοκύτταρα παράγουν αντισώματα ή και απλά τμήματα αντισωμάτων –τις λεγόμενες παραπρωτεϊνες. Παράγονται από έναν κλώνο πλασματοκυττάρων και έτσι λέγονται μονοκλωνικές πρωτεΐνες, γιατί όλα τα πλασματοκύτταρα παράγουν την ίδια παραπρωτεΐνη. Αυτά τα αντισώματα έχουν όλα τις ίδιες φυσικοχημικές ιδιότητες, έτσι στην εξέταση που ονομάζεται ηλεκτροφόρηση πρωτεϊνών (ή λευκωμάτων ) εμφανίζονται σαν μια ομογενής πυκνή περιοχή.
Η αναπαραγωγή αυτών των κακοήθων πλασματοκύτταρων μέσα στον μυελό των οστών παρεμποδίζει την λειτουργία του φυσιολογικού μυελού των οστών. Παρεμποδίζεται η ανάπτυξη και ωρίμανση των αιμοτοποιητικών κυττάρων στο μυελό των οστών ώστε αναπτύσσεται αναιμία ή χαμηλά αιμοπετάλια (θρομβοπενία).

Ο πολλαπλασιασμός των κυττάρων του μυελώματος μέσα στον μυελό των οστών, οι αλληλεπιδράσεις τους με τα άλλα κύτταρα του μυελού των οστών και η ενεργοποίηση κυττάρων του ανοσοποιητικού συστήματος έχουν ως αποτέλεσμα την ενεργοποίηση των οστεοκλαστών.
Οι οστεοκλάστες είναι κύτταρα τα οποία διασπούν την οστέινη ουσία των οστών (απορροφούν το οστό) και αυξάνεται η δραστηριότητα τους από ουσίες που εκκρίνονται από τα κακοήθη πλασματοκύτταρα. Οι οστεοβλάστες είναι τα κύτταρα εκείνα που αναδομούν («κτίζουν») το οστό. Οι οστεοβλάστες καταστέλλονται από ουσίες που παράγουν τα πλασματοκύτταρα. Έτσι διαταράσσεται ο φυσιολογικός κύκλος του οστού (οστικός μεταβολισμός) με αποτέλεσμα μεγάλη απώλεια οστικής μάζας και βλάβες των οστών, που μπορούν να προκαλέσουν κατάγματα και πόνους.
Η διάλυση του οστικού ιστού απελευθερώνει αυξανόμενες ποσότητες ασβεστίου. Η αύξηση της συγκέντρωσης ασβεστίου στο αίμα (υπερασβεστιαιμία) μπορεί να προκαλέσει διάφορες επιπλοκές, όπως βλάβες των νεφρών, κόπωση, σύγχυση, καρδιακές αρρυθμίες, ναυτία και έμετο.
Πολλαπλό μυέλωμα: Τα συμπτώματα και τα αίτια
Η παραγωγή μεγάλων ποσοτήτων παραπρωτεϊνών, και κυρίως ορισμένων τμημάτων που λέγονται ελαφρές αλυσίδες, μπορεί να προκαλέσει απόφραξη των νεφρικών σωληναρίων, με συνέπεια την βλάβη της λειτουργίας των νεφρών. Συχνά η νεφρική ανεπάρκεια αποτελεί τον πρώτο εύρημα για την διάγνωση του μυελώματος
Η παραγωγή των παραπρωτεϊνών εμποδίζει τον σχηματισμό φυσιολογικών αντισωμάτων, καθιστώντας τον ασθενή πιο επιρρεπή σε λοιμώξεις.
Το πολλαπλό μυέλωμα δεν είναι σπάνια νόσος, καθώς αντιστοιχεί περίπου στο 10% του συνόλου των αιματολογικών κακοηθειών.
Οι περισσότεροι άρρωστοι με μυέλωμα εμφανίζονται κατά την διάγνωση με συμπτώματα, σημεία και εργαστηριακά ευρήματα ενεργής νόσου όπως επώδυνες οστεολυτικές βλάβες (πόνους στα οστά, την μέση, κατάγματα), υπερασβεστιαιμία, αναιμία και νεφρική ανεπάρκεια.
Υπάρχουν διάφορες μορφές πολλαπλού μυελώματος που διαφέρουν μεταξύ τους στη δομή των παραγομένων αντισωμάτων.
Το πολλαπλό μυέλωμα μπορεί να υφίσταται επί σειρά ετών χωρίς εμφανή συμπτώματα ασθένειας. Κατά κανόνα, τα συμπτώματα της ασθένειας που περιγράφουμε εδώ δεν εμφανίζονται παρά μόνο αφού η ασθένεια υφίσταται για μεγάλο χρονικό διάστημα.
Το ερώτημα, γιατί αναπτύσσεται το πολλαπλό μυέλωμα παραμένει μέχρι και σήμερα κατά το μεγαλύτερο μέρος αναπάντητο.
Αν και η νόσος παρατηρείται πιο συχνά μεταξύ στενών συγγενών (γονείς/αδέλφια), το πολλαπλό μυέλωμα δεν αποτελεί μια κληρονομική ασθένεια με την στενή έννοια του όρου.
Πηγή: ΕΚΠΑ